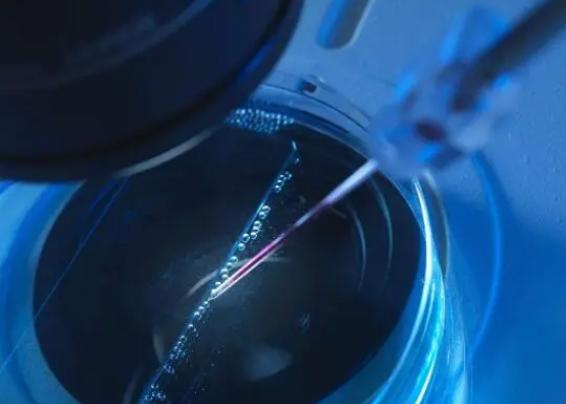
泰国试管婴儿全攻略，带你实现父母之梦

更新时间:2023-11-20
近年来由于国内政策的限制,不少想要生育孩子的家庭开始选择出境到海外进行试管婴儿。其中,泰国成为了许多人的助孕之地。但是去泰国做试管婴儿究竟有哪些流程?需要注意哪些细节呢?本文将为您一一道来!
首位步:选择医院
去泰国做试管婴儿,首先要选好医院。目前在泰国进行试管相关项目的医院有很多,但是还是建议大家选择一些较为知名的医疗机构,比如曼谷华南医院、曼谷Ramathibodi Hospital等等。
第二步:预约挂号
预约挂号也是非常重要的一个环节,可以通过官网或者电话联系医院进行预约挂号。在预约时需要提供个人信息以及旅行时间等相关细节。
第三步:初诊与检查
初诊与检查主要是针对夫妇双方进行身体检查和评估是否适合试管。在初诊时需要提供身份证明、血液检查报告、B超等相关检查材料。
第四步:签订合同
在确定进行试管婴儿之后,需要签订相关合同。合同中会明确医院的责任以及医疗费用等相关事宜。
第五步:取卵和精子
取卵和精子是整个试管过程中比较为关键的环节之一。女方需要进行促排卵治疗,通过B超和内窥镜来确定排卵时间。男方则需要提供新鲜精液或冷冻精液。
第六步:受孕过程
受孕过程主要是将男方提供的精子与女方取出的卵子结合,并培养成胚胎。然后再将胚胎移植到女方体内,进行着床和生长发育。
第七步:观察和调理
在胚胎移植后,需要观察和调理一段时间。这段时间内主要是通过荷尔蒙治疗来保证孕育成功。
小提示:以上就是去泰国做试管婴儿的流程,相信大家已经对此有了更为清晰的认识。如果您想要生育孩子,试管婴儿是一种很好的选择。但是需要注意的是,在出境前一定要了解相关政策和手续,以免耽误时间和增加费用。
以上就是医院招聘网小编为大家整理的《泰国试管婴儿全攻略,带你实现父母之梦》相关信息,希望大家喜欢。
内容版权声明:本网站部分内容由网上整理转发,如有侵权请联系管理员进行删除.